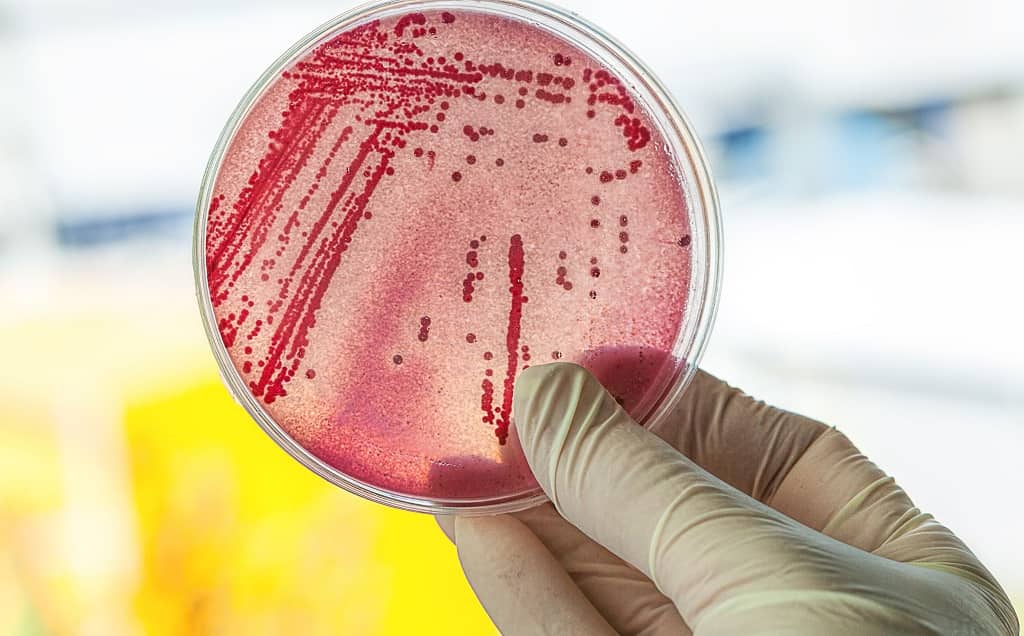

微生物實驗室品質管理師 證照訓練班
主辦單位:TTQAS 社團法人台灣檢驗及品保學會及國立陽明大學微免科所
有鑑於
- 考試院舉辦的食品技師高考因應食品安全需求,將增加名額
- 協助食品業者 QC/QA 檢驗室主管及從業人員符合衛福部的要求「新進的微生物檢驗室人員、檢驗部門主管、報告簽署人及品質主管需接受 60 個小時的教育訓練」(參閱衛福部公告公告「實驗室品質管理規範-微生物領域測試結果之品質管制」)
- 連結大學之食品科系的教育訓練與企業需求,讓有興趣的職場新鮮人及食品業界瞭解食品微生物檢驗技術及品管的新趨向,食品安全觀念及發揮教學與應用雙贏的策略
TTQAS 為了邁向這些目標,特別舉辦為期 6 天的研習會,將以實作教學方法,讓學員實際操作基本食品微生物檢驗技術,並且除了介紹及解讀公告的食品衛生指標、病原菌檢驗及鑑別與微生物保健食品檢測外,亦將介紹大陸各類食品微生物檢測項目、台灣飲料衛生安全標準等以及提供 2019 新出版的專業書籍「食品微生物檢驗技術」。
證照訓練班說明,通過考試者頒發中級證照
預期收獲:參加者將可以獲得食品微生物檢驗的基本操作技術,認識食品衛生指標及食源性微生物中毒的作用機轉,分子診斷學原理及操作法,食品微生物危害風險評估,了解耐酸 / 耐熱黴菌 / 平酸菌 / 腐敗菌、解讀衛福部公告的所有食品微生物檢驗方法、了解快速偵測套組、快速計數、自動化鑑定、電腦密碼鑑定系統的應用、瓶裝水衛生檢測、ICMSF 建議之各類食品的微生物限量標準、實驗室實作技巧等,參加學員將可把所學實際應用於提升廠家產品的品質,避免食安問題的發生,以及有益於參加國家食品技師相關高等證照考試。
適合對象:報名者限食品業界新進的微生物檢驗室人員、檢驗部門主管、報告簽署人及品質主管,即將畢業的大專相關科系學生,公家機構以及學術單位有興趣的人員,非上述人員請勿報名。
學分及證書:受訓者將依實際上課時數給予繼續教育時數證明。另外,凡受訓滿 40 小時以上,若通過筆試及實作考試者將頒發「微生物實驗室品質管理師中級」證照。
舉辦時間:2019年10月26日(六)、2019年10月27日(日)、 2019年11月9日(六)、2019年11月16日(六)、2019年11月17日(日)
考試日期:2019年11月30日(六) (考試包括筆試及實驗室實作跑考) 。
舉辦地點:國立陽明大學實驗大樓三樓微生物實驗室(台北市北投區立農街二段 155 號)。
參加費用:費用包含講義、午餐、茶點、實驗材料費 (26,000元 / 機構) 、書籍「食品微生物檢驗技術」(定價2,000元)、書籍「細菌名稱及分類鑑定」 (定價1,000元) 及雜誌「檢驗及品保」(定價600元)。
-
- 早鳥價:9月27日 (五) 前完成報名,報名費優待為 14,500 元/人,可免費參加 10/5 (六) 之「創新食品 (保健食品) 的開發及衛生安全檢驗論壇」(需預先完成報名,活動網址)。
- 團報價:同一單位 2 名以上人員報名,報名費優待為 14,500 元/人。
- 學生價:食品科學系在校學生 12,500元/人 (需提供註冊證明)。
- 一般價:15,500元/人。
招生人數:60名。
線上報名:https://forms.gle/wqEWa9YNDMFN7PtQ7,報名後即可繳費,請將收據或帳號後 5 碼 Email 至 ttqaa@gmail.com 或傳真至 TTQAS學會 (傳真:02-2290-2510) ,請註明您的單位及姓名,繳費後恕不退費,但可由公司同仁取代,如要更換學員名稱請洽 TTQAS 幹事范小姐 (電話:02-2298-9459)。
截止日期:10月15日(一)止,額滿截止,若報名人數不足 30 名,將取消研習會全額退費。
繳款資訊:
銀行:合作金庫(006)
帳號:5403-717-304221
分行:五股工業區分行
戶名:社團法人台灣檢驗及品保學會
證照訓練班課表
| 日期 | 時間 | 主題 | 講師 |
|---|---|---|---|
| 10 月 26 日 (六) | 08:30~08:50 | 報到 | 秘書處 |
| 08:50~09:00 | 致歡迎詞 | ||
| 09:00~09:40 | 由食品中毒不同病原細菌之特性及所引起的病徵談導致食品中毒食品的選擇 | 蔡文城 教授 | |
| 09:40~10:40 | 食品微生物檢驗各類檢體的採集與製備 (請參考 食品微生物檢驗技術 第5章) | 蔡文城 教授 | |
| 10:40~11:00 | 休息 (合照留念) | ||
| 11:00~12:00 | 飲料的最新衛生安全標準及檢測技術 | 台美檢驗 張雅迪 組長 |
|
| 12:00~13:00 | 午餐 | ||
| 13:00~17:00 | 食品微生物檢驗基本技術及實作: (請參考 食品微生物檢驗技術 第3及第4章) | 蔡文城 教授 張雅迪 組長 歐柏廷 碩士 鄭守程 專員 |
|
| 10 月 27 日 (日) | 08:20~08:40 | 報到 | |
| 08:45~09:35 | 解讀衛福部公告方法: 乳酸菌檢驗 (計數) 以及 乳酸菌的鑑定: 套組、分生、傳統表型技術 (請參考 食品微生物檢驗技術 第35章) | 蔡文城 教授 | |
| 09:35~10:15 | 公告方法食品衛生指標菌及包裝飲用水、 綠膿桿菌、糞便性鏈球菌及衛生指標菌檢驗 (請參考 食品微生物檢驗技術 第13~15章) | 蔡文城 教授 | |
| 10:15~10:35 | 休息 | ||
| 10:35~12:00 | (請參考 食品微生物檢驗技術 第4章、第7章及第3章) | 蔡文城 教授 | |
| 12:00~13:00 | 午餐 | ||
| 13:00~13:50 | 飲料及罐頭各種平酸菌及嗜熱耐酸腐敗菌的檢測 (再參考 食品微生物檢驗技術 第38章) | 台美檢驗 劉梅玉 協理 |
|
| 13:50~16:45 | (判讀革蘭氏染色、觸酶試驗、乳膠凝集試驗、 菌落特徵觀察: 溶血性、顏色、大小、 形狀 : A 群鏈球菌、產氣莢膜梭菌、李斯特菌、金葡等) | 蔡文城 教授 劉梅玉 協理 歐柏廷 碩士 鄭守程 專員 |
|
| 11 月 09 日 (六) | 08:30~09:00 | 報到 | |
| 09:00~09:50 | 食品微生物檢驗方法之發展趨勢及 直接從食品中快速偵測衛生指標菌和病原菌的新設計 (請參考 食品微生物檢驗技術 第32章) | 啟新生物 林函頤 協理 |
|
| 09:50~12:00 | RapidChek & R-biopharm (實作/示教) Thermo latex test, RapID & API 系統 (實作/示教) | 黃依柔 碩士 / 副理 洪晟峯 處長 |
|
| 12:00~13:00 | 午餐 | ||
| 13:00~14:00 | Thermo SureTect real-time PCR system (實作) | 楊士杰 碩士 / 副理 | |
| 14:00~15:00 | 衛生指標菌之快速計數: Bio-Theta DOX & CompactDry (實作/示教) | 黃依柔 碩士 / 副理 | |
| 15:00~15:20 | 休息 | ||
| 15:20~16:00 | 培養基品質與效能驗證 | 林函頤 協理 | |
| 16:00~17:00 | 食品微生物檢測方法選擇要點 | ||
| 11 月 16 日 (六) | 08:30~09:00 | 報到 | |
| 09:00~09:50 | 建立優良食品微生物實驗室 (請參考 食品微生物檢驗技術 第2章) | 蔡文城 教授 | |
| 09:50~10:40 | ISO 17025認證實驗室現場評鑑常見問題及案例分析 | 陽明大學 生化所 張勝祺 教授 |
|
| 10:40~11:00 | 休息 | ||
| 11:00~11:50 | 生菌數、黴菌及酵母菌之計數、大腸桿菌群、 腸桿菌科及大腸桿菌之公告方法導讀 (請參考 食品微生物檢驗技術 第8~12章) | 蔡文城 教授 | |
| 11:50~12:30 | 各種耐熱黴菌及一般黴菌與酵母菌的基礎實驗室診斷技術 (請參考 食品微生物檢驗技術 第37及38章) | ||
| 12:30~13:30 | 午餐 | ||
| 13:30~15:00 | 健康食品之功效性評估 | 臺大 生化科技學系 潘子明 特聘教授 |
|
| 15:00~15:30 | 休息 | ||
| 15:30~16:30 | 食品中毒病原中各種革蘭氏陰性桿菌檢驗方法之導讀 (請參考 食品微生物檢驗技術 第16~25章) | 蔡文城 教授 | |
| 16:30~17:00 | 從新聞報導談食品衛生安全 | 蔡文城 教授 | |
| 11 月 17 日 (日) | 08:20~08:45 | 報到 | |
| 08:45~09:45 | (請參考 食品微生物檢驗技術 第36章、第43章) | 蔡文城 教授 | |
| 09:45~10:00 | 休息 | ||
| 10:00~12:00 | 食品中毒病原中各種革蘭氏陽性菌檢驗方法之導讀 (請參考 食品微生物檢驗技術 第26~31章) | 蔡文城 教授 | |
| 12:00~13:00 | 午餐 | ||
| 13:00~14:00 | 食品中毒病原細菌及病毒的分子診斷 (包括新公告之食源性中毒細菌的分子診斷法) (請參考 食品微生物檢驗技術 第33及34章) | 台美檢驗 詹孟翰 主任 |
|
| 14:00~15:00 | (請參考 食品微生物檢驗技術 第44章、第45章) | 蔡文城 教授 | |
| 15:00~15:20 | 休息 | ||
| 15:20~16:45 | ICMSF建議各類食品的微生物限量標準及檢驗方法應用之導讀 (請參考 食品微生物檢驗技術 第42章) | 蔡文城 教授 | |
| 11 月 30 日 (六) | 08:30~09:00 | 報到 | |
| 09:00~12:00 | 食品微生物檢驗技術: 實驗室跑考 (佔30%) 監考:蔡文城教授、林錫斌教授及歐柏廷碩士 | ||
| 12:00~12:30 | 筆試 (佔70%) (請參考歷屆微生物學程考題共600題,但題目均重新出題) |

你必須登入才能發表留言。